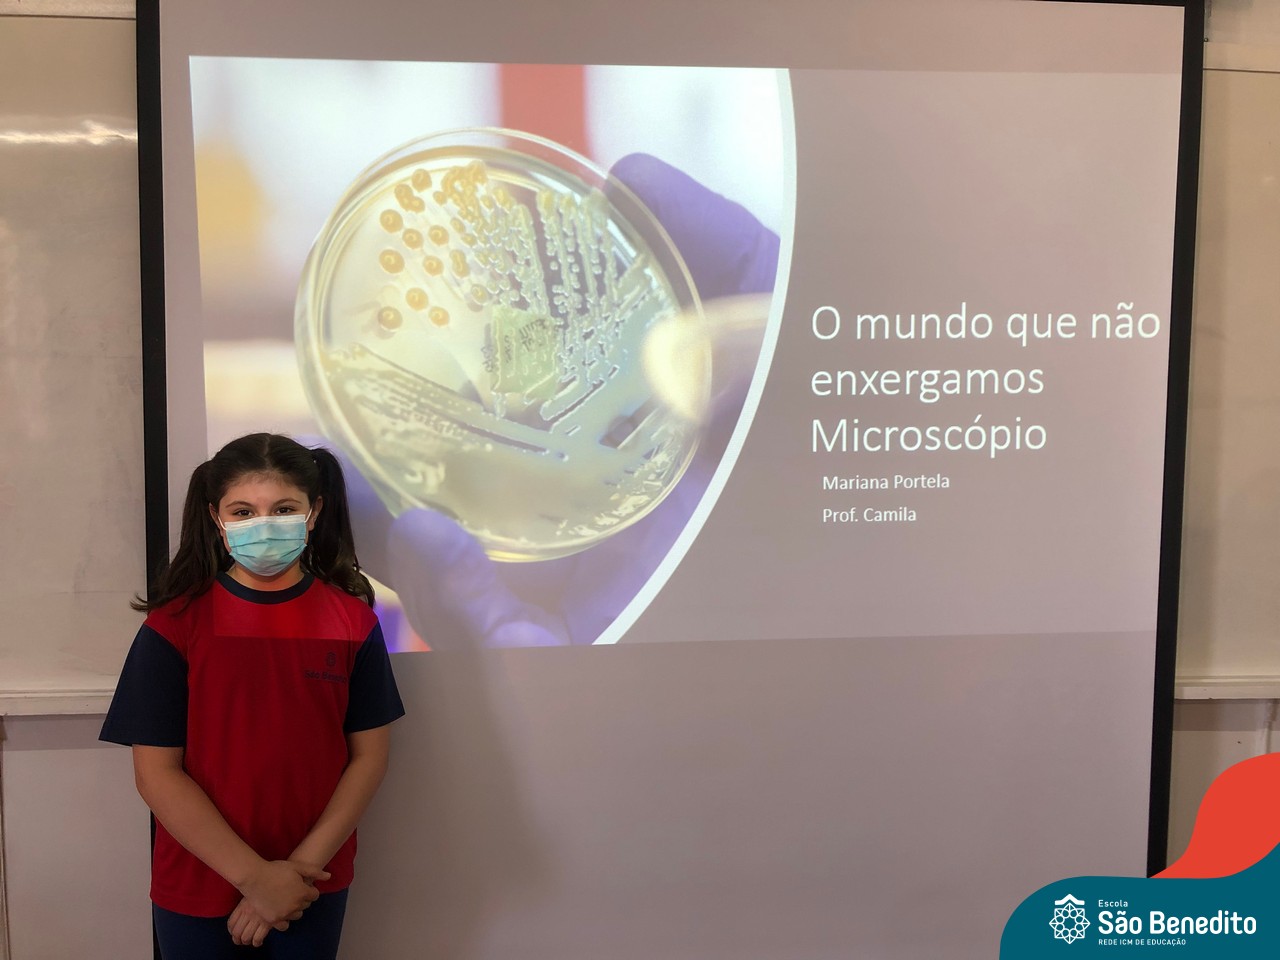

Os estudantes da turma 41, comandados pela professora Camila Mércio, realizaram o penúltimo projeto de ciências do ano letivo. De forma extraordinária, o tema foi livre, o que fez com que todos soltassem a imaginação e a criatividade. E os resultados não negam o empenho de cada um: Teve simulação do dia e da noite, e muita experiência!
Parabéns aos nossos pequenos grandes cientistas!